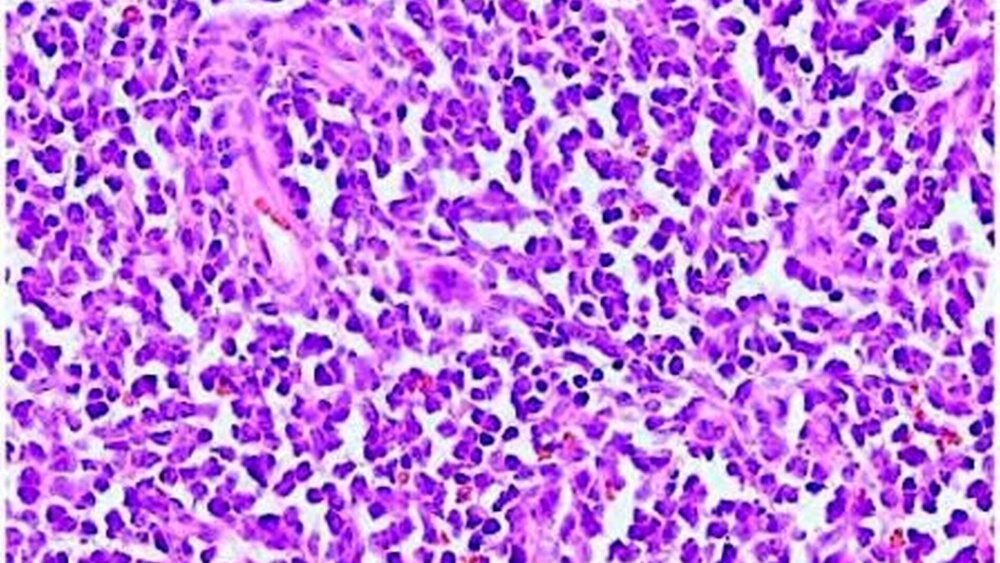

Infiltrate einer akuten myeloischen Leukämie
Eine 49-jährige Patientin, starke Raucherin, wurde mit der histologisch abgesicherten Diagnose einer schwergradigen chronischen Osteomyelitis des linken Oberkiefers vorgestellt. Im Verlauf der letzten drei Monate waren mehrfach Antibiotikatherapien und Dekortikationen durchgeführt sowie die Zähne 25 bis 28 extrahiert worden. Extraoral fiel eine Gesichtsasymmetrie mit Schwellung der linken Wangenregion (Abbildung 1) auf. Die Patientin berichtete über ein zunehmendes Taubheitsgefühl und neuralgiforme Schmerzen im Versorgungsgebiet des Nervus infraorbitalis links. Der zuweisende MKG-Chirurg hatte bereits Zweifel an der auswärtigen histologischen Diagnose, da die Patientin neben der lokalen Symptomatik im Oberkiefer ein kontinuierlich größenprogredientes, derbes, nicht verschiebliches und nicht schmerzhaftes Lymphknotenkonglomerat entwickelt hatte. Er vermutete daher ein neoplastisches Krankheitsbild.
Intraoral zeigte sich eine Auftreibung des Alveolarkamms (Abbildung 2), die nach palatinal zu einer Abflachung des Gaumengewölbes führte. Besonders auffällig war die pathologische Gefäßzeichnung am Übergang von Hart- zu Weichgaumen. Hier fanden sich massiv vermehrte und ektatische Gefäße in der Schleimhaut.
In der weiterführenden computertomographischen Diagnostik (Abbildung 3). stellte sich eine den Oberkieferknochen destruierende Raumforderung mit vollständiger Verlegung der linken Kieferhöhle dar. Sonographisch (Abbildungen 4a und 4b) zeigte sich eine echoarme, aber noch gut begrenzte Lymphknotenformation, deren Gefäßstrukturen in der Peripherie verdrängt erschienen.
Das bioptisch gewonnene Material (Abbildung 5) imponierte als festes, fast schwartenartiges Gewebe ohne richtungsweisende makroskopische Merkmale. Histologisch (Abbildung 6) zeigte sich eine diffuse Infiltration des Gewebes mit einer monomorphen Zellpopulation blastenartiger Zellen. Unter der weiteren immunhistologischen Diagnostik wurde abschließend die Diagnose einer akuten myeloischen Leukämie gestellt.
Die Patientin wurde daher zur internistischonkologischen Behandlung weitergeleitet.
Diskufssion
Der Begriff „Leukämie“ (weißes Blut) ergibt sich aus der Beobachtung einer Vermehrung der weißen Blutkörperchen (Leukozyten) im Blut. Er wurde erstmals von Virchow 1845 verwendet. Akute Leukämien sind hochmaligne Stammzellerkrankungen der Hämatopoese. Durch klonale Expansion unreifer hämatopoetischer Zellen (Blasten) kommt es zur Verdrängung der normalen Blutbildung im Knochenmark mit konsekutiver Anämie, Neutropenie und Thrombozytopenie. Beim Erwachsenen sind rund 80 Prozent der akuten Leukämien myeloischen und 20 Prozent lymphatischen Ursprungs.
Die jährliche Inzidenz der akuten myeloischen Leukämie (AML) beträgt 2,5/100 000 und steigt altersabhängig bis 12-13/100 000 bei über 65-jährigen Patienten. Das mediane Alter bei Diagnose einer AML liegt bei 62 Jahren [Löwenberg et al., 1999].
Die Beschwerden sind unspezifisch und die Anamnese ist in der Regel kurz (wenige Wochen). Hauptsymptome sind grippeähnliche Beschwerden, Infekte der oberen Luftwege, Fieber, Müdigkeit, ein Leistungsknick, seltener mukokutane Blutungen (Zahnfleischbluten, Epistaxis, Petechien, Suffusionen). Die klinischen Befunde sind bedingt durch die Akkumulation der leukämischen Blasten im Knochenmark mit konsekutiver Anämie, Granulozytopenie und Thrombozytopenie, weniger häufig durch eine leukämische Infiltration von Geweben. Spezifische klinische Befunde sind die Ausnahme. Diagnostisch wegweisend ist in erster Linie das pathologische Blutbild. Eine Anämie und/oder Thrombozytopenie findet sich bei der Mehrheit der Patienten, die Leukozyten können vermindert, normal oder erhöht sein. Die Differenzierung der Leukozyten und die Beurteilung des Blutausstrichs führen zur Diagnose. Abschließend beweisend für die Diagnose einer akuten Leukämie ist der Nachweis einer unreifen leukämischen Zellpopulation, der grundsätzlich anhand von Knochenmark beziehungsweise peripherem Blut erfolgt.
Sehr selten (etwa ein bis drei Prozent der Fälle) sind primär extramedulläre Leukämien wie in diesem Fall. Diese klinisch eher einem soliden Tumorwachstum entsprechende Verlaufsform wird auch als granulozytisches Sarkom, myeloides Sarkom, extramedullärer myeloider Tumor oder wegen der manchmal grünlichen Farbe im Gewebeanschnitt als Chlorom bezeichnet [Antmen et al., 2003; Xie et al., 2007].
Obwohl die Klinik dieser Läsionen insgesamt sehr unspezifisch ist, zeigen sich auch am vorliegenden Fall einige typische Alarmsymptome, die den Verdacht auf eine neoplastische Erkrankung lenken müssen. So zeigte sich hier eine sehr prominente pathologische Gefäßzeichnung der Mukosa, die typischerweise auf eine tumorinduzierte Gefäßneubildung (Neoangiogenese) hinweist. Als zweites Leitsymptom wies die Patientin eine kontinuierlich progrediente, derbe, schmerzarme Lymphknotenschwellung auf. Darüber hinaus lag eine Gefühlsstörung im Versorgungsgebiet des N. infraorbitalis vor, die auf eine Infiltration der Nerven schließen ließ. Schließlich führte die Ausschaltung vermeintlicher Ursachen einer entzündlichen Erkrankung (Zahnsanierung) nicht zur Rückbildung der Läsion.
Diese Konstellation machte es zwingend erforderlich, auch eine im Vorfeld histologisch vermeintlich abgesicherte Diagnose zu hinterfragen.
Dr. Dr. Hendrik FuhrmannProf. Dr. Dr. Martin KunkelKlinik für Mund-, Kiefer- undplastische GesichtschirurgieRuhr-Universität BochumKnappschaftskrankenhausBochum-LangendreerIn der Schornau 23-2544892 Bochumhendrik.fuhrmann@kk-bochum.demartin.kunkel@ruhr-uni-bochum.de